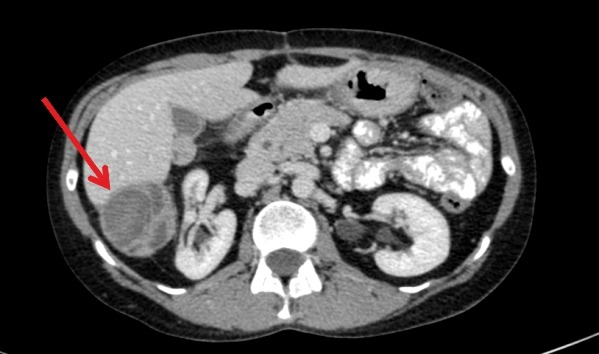
Симптомы

Метастазы в печени: симптомы и прогноз
Злокачественная опухоль существенно отличается от здоровой ткани, которая ее окружает. Ее клетки способны делиться неограниченное количество раз. На определенной стадии они начинают отрываться от новообразования и распространяться по организму, образуя вторичные очаги роста – метастазы (от греческого metastasis – перемещение). Структура дочерней опухоли обычно не отличается первичной. Современной медициной изучено несколько путей миграции патологического материала. Основные из них:
- Гематогенный (диссеминирование по кровеносным сосудам)
- Лимфогенный (транспортирование по лимфатической системе)
- Имплантационный (результат контакта с воспринимающей поверхностью)
Метастазирование по кровеносной системе возможно практически в любой орган, но наиболее частыми мишенями становятся легкие и печень.
Пути метастазирования в печень
Детоксикационная функция печени – фильтрация венозной крови, поступающей из органов желудочно-кишечного тракта, поджелудочной железы, селезенки, желчного пузыря (система воротной вены). Интенсивность кровообращения (более 1,5 литров в минуту), замедление кровотока в синусоидных капиллярах создают благоприятные условия для оседания и размножения опухолевых клеток. При поражении любого органа системы воротной вены повышается вероятность попадания метастазов в печень.
Поражения могут быть одиночными или множественными, но проявляются не сразу и протекают бессимптомно. Опасны тем, что сам орган обладает высокой регенеративной способностью, а факторы местного иммунитета могут временно блокировать активность вторичных очагов. Через какое время они проявят себя – неизвестно, у каждого организма все индивидуально. Механизм запуска роста дочерних поражений не изучен в достаточной мере, но рост числа клеток говорит о долгосрочности первичного процесса, прогрессировании заболевания.
Опухоли каких органов могут метастазировать в печень?
- пищевод,
- желудок,
- толстая кишка,
- поджелудочная железа,
- молочная железа,
- легкие.
Симптомы и диагностика
Неспецифичность симптоматики опухолевого поражения может затруднить раннюю диагностику. Что должно насторожить?
- Болевые ощущения в правом подреберье,
- Диспепсия (расстройство пищеварения),
- Резкая потеря веса,
- Кожный зуд,
- Желтуха,
- Расширение поверхностных вен, водянка живота,
- Дисфункция кишечника и др.
Метастазы в печени на УЗИ
Ультразвуковая диагностика не способна дать полную информацию. Для изучения морфологического строения клеток, их типа и зрелости, возможно проведение УЗИ с биопсией. Получение образцов ткани на цитологическое и гистологическое исследование проводится безопасным забором при помощи игл различного диаметра. Биопсия метастазов в печени позволяет установить локализацию первичной опухоли. Это особенно важно в случаях невыявленных первичных поражений. Проведение биопсии безвредно и не оказывает влияния на увеличение скорости метастазирования.
Уточнить величину, локализацию, распространение, характер роста, наличие некротизированной ткани, абсцесса, инфильтрацию в органы – позволяют современные методы рентген-диагностики:
- Компьютерная мультиспиральная томография
- Магнитно-резонансная томография
- Ангиографическое исследование,
- Позитронно-эмиссионная томография.

С помощью этих методов, по степени уменьшения очага воспаления, можно также контролировать динамику заболевания.
Прогноз эффективности
Своевременная терапия дает положительный результат в большинстве случаев. Проведение консервативного лечения может быть осложнено чувствительностью органа к лекарству. Введенные противоопухолевые препараты разрушают активно делящиеся клетки, замедляют рост опухоли. Проведение терапии позволяет уменьшить размер новообразования для последующего хирургического вмешательства. Одиночные метастазы рака удаляются хирургически. Правильное питание, образ жизни, распорядок дня – составляющие части комплексной терапии.
Прогноз эффективности лечения во многом зависит от фенотипа, характера поражения, числа метастатических узлов и локализации первичной опухоли. Метастазы опасны риском внутренних кровотечений, сдавлением кровеносных сосудов, токсическим повышением уровня билирубина, нарушением оттока желчи.
Наличие внепеченочных метастазов, множественные запущенные поражения печени, к сожалению, дают неблагоприятный прогноз.
Основные методы лечения
Стратегию лечения согласовывают в зависимости от количества очагов поражения, типа рака, степени нарушения функционирования печени и других поврежденных органов. Активное вмешательство, терапия и прочие методы способствуют продлению жизни и существенному улучшению ее качества. Комплекс процедур может включать:
- Химиотерапию,
- Лучевую терапию,
- Оперативное вмешательство.
Если вы хотите узнать побольше о бесплатных возможностях ФБГУ НМИЦ онкологии им. Н.Н. Петрова Минздрава России, получить очную или заочную консультацию по диагностике и лечению, записаться на приём, ознакомьтесь с информацией на странице.
Если вы хотите общаться с нами через социальные сети, обратите внимание на аккаунты в ВКонтакте и Telegram.
- «99 процентов работы патологоанатома — это прижизненная диагностика». Заведующая патологоанатомическим отделением НМИЦ онкологии им. Петрова Анна Сергеевна Артемьева — о тайнах профессии
- Саркома Юинга: диагностика и лечение
- «Мечтаю о рождении первых детей»: онкогинеколог и репродуктолог Ольга Евгеньевна Лавринович – о себе и программе отложенного родительства для онкологических пациентов
- «Шока не было. Болезнь я восприняла как испытание»: 20-летняя Даша борется с острым лимфобластным лейкозом и не прекращает учебу
- «Читаем мысли хирурга». Старшая медсестра оперблока Центра Галина Мусий — о себе и профессии